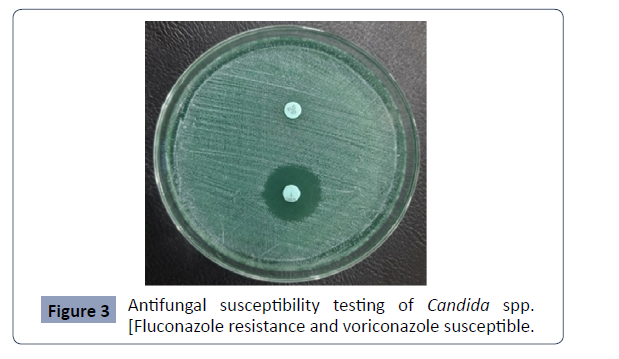

Abstract
The effective management of Candiduria depends upon proper identification of Candida species and their antifungal susceptibility test. Therefore, this cross-sectional study is conducted to assess the occurrence of different Candida species in urine and determine their antifungal susceptibility pattern from productive age group 15- 65. The isolation and identification of Candida species from clean catch midstream urine were done by culturing on Sabouraud Dextrose Agar with chloramphenicol followed by germ tube test, sugar fermentation test, chlamydospore production test, and further differentiated by using CHROM agar. The antifungal susceptibility test was done on Muller Hinton Agar with 2% glucose and 0.5 µg/mL methylene blue, and result interpretation was done as recommended to CLSI guidelines (M 44-A2). Candida parapsilosis (14, 31.1%) and C. albicans (12, 26.67%) were the two most common isolates. From 586 urine samples, 45 Candida species were isolated in which the predominant one is C. parapsilosis (14, 31.1%) followed by C. albicans (12, 26.6%). The antifungal susceptibility test showed that fluconazole resistant (29.41%) was comparatively more than voriconazole (21.87%). Since non albicans Candida are emerging pathogen and its antifungal resistant pattern is hiking, it is crucial to incorporate fungus identification in routine testing and identify their antifungal susceptibility pattern to ensure effective treatment and monitor for any antifungal resistance.
Keywords
Candiduria; Candida parapsilosis; Fluconazole; Voriconazole
Introduction
Candiduria refers to the presence of Candida species in urine
causing urinary tract infections [UTIs] which should not
be neglected or treated hastily in both asymptomatic and
symptomatic cases of UTI [1]. In UTI, the most dominating fungus
is Candida albicans but some report shows a significant increase of
“Non albicans Candida (NAC) [2]. Further, recent study has shown
that candiduria is becoming more common than bacteriuria in
immunocompromised patients [3].
The lack of standardized laboratory diagnosis and treatment
options is a contentious issue surrounding candiduria. Many cases
of candiduria are asymptomatic, making it difficult to determine
whether the presence of Candida in urine indicate a true infection
or simply colonization of urinary tract, as it is a normal flora of
the urinary tract [1]. Hence, infections due to Candida species
are largely a condition associated with medical progress and are
widely recognized as a major cause of mortality and morbidity in
the healthcare environment. The emergence of fungal infections
is highly problematic and may be attributed due to the extensive
use of broad-spectrum antibiotics and immune-suppressive
agents, as well as an increase in immunocompromised individuals
with autoimmune diseases, cancers, and transplants [4]. Thus,
proper diagnosis and susceptibility testing of Candida species
in clinical specimens has become increasingly important for the
management of fungal infections.
In Nepal, the field of mycology faces limitation due to the scarcity
of sophisticated healthcare facilities and lack of awareness in the
community. Consequently, managing candiduria in asymptomatic
and symptomatic individuals has become a challenging task. So,
this descriptive cross-sectional study was conducted to assess
candiduria with antifungal susceptibility patterns for better
management and treatment strategies.
Material and Methods
A total of 586 clean catch midstream urine samples (CCMSU) were
collected from 1st April 2021 to 30th June 2021. The homogenized
urine sample (4 μL) was streaked on SDA agar with 0.5 mg per
1000 mL chloramphenicol and incubated at 37°C. The culture
plates were examined for growth at 24 hrs, 48 hrs and 72 hrs.
Since there is no established guideline for candiduria similar to
bacteriuria, a lower cut-off value of 103 CFU/mL was adopted as described elsewhere [5 ]. The colony characteristics of the yeast
colonies were examined for preliminary identification. Additional
tests such as Gram staining, colony morphology on Cornmeal
agar, germ tube test, sugar fermentation test and CHROM agar
test were done to aid in the identification of yeast.s
The Antifungal Susceptibility Test (AFST) was done on Mueller-
Hinton agar supplemented with 2 % glucose and 0.5 μg/
mL methylene blue dyes. Antifungal disks (fluconazole and
voriconazole) were placed on the surface of each agar plate and
incubated aerobically at 37℃ for 24-48 hrs. The zone size was
interpreted based on CLSI guidelines [6].
All the data were input in SPSS version 23 for descriptive statistical
analysis.
Results
This trimester study includes 586 urine samples from which
45 Candida species were isolated. Overall, there were a higher
number of female participants compared to male participants
and concomitantly the number of isolates from the female was
also three times more than males. The age group 30-40 covers
most of the samples and two out of 10 patients with antifungal
treatment have fungal growth (Table 1).
| Variables |
Growth of Candida |
Total |
| Yes |
No |
Insignificant |
|
| Sex |
Male |
11 |
153 |
12 |
176 |
| Female |
34 |
355 |
21 |
410 |
| Total |
45 |
508 |
33 |
586 |
| Age group |
< 20 |
2 |
16 |
2 |
20 |
| 20-30 |
8 |
136 |
9 |
153 |
| 30-40 |
16 |
133 |
5 |
154 |
| 40-50 |
9 |
116 |
7 |
132 |
| >50 |
10 |
107 |
10 |
127 |
| Total |
45 |
508 |
33 |
586 |
Antifungal
Treatment |
Yes |
2 |
5 |
3 |
10 |
| No |
43 |
503 |
30 |
576 |
| Total |
45 |
508 |
33 |
586 |
Table 1.Socio-Demographic and Clinical Characteristics of Participants
Among the Candida species, C. parapsilosis (31.1%, 14) and C.
albicans (26.6 %, 12) were the two most frequent isolates. The
overall distribution of isolates is present in Figures 1 and 2.
Figure 1: Displays the presence of both chlamydospores and
blastospores.
Figure 2: Chlamydospore and blastospore from Cornmeal agar.
In this study, two antifungal agents; Fluconazole and Voriconazole,
were tested to determine antifungal susceptibility pattern of
isolates in which Voriconazole was found as more susceptible
than Fluconazole. The overall susceptibility pattern of Candida
species to different antifungal agents is shown in Table 2 and
AFST of Candida species were shown in Figure 3.
| Antifungal |
|
Candida |
|
|
|
|
Total |
| agents |
|
albicans |
tropicalis |
glabrata |
parapsilosis |
krusei |
|
| Fluconazole (10µg) |
S |
8 |
3 |
0 |
8 |
- |
19 |
| |
|
-66.60% |
-75.00% |
|
-57.10% |
|
-55.80% |
| |
SDD |
2 |
1 |
2 |
2 |
- |
7 |
| |
|
-16.60% |
-25% |
-50% |
-14.20% |
|
-20.50% |
| |
R |
2 |
0 |
2 |
4 |
- |
10 |
| |
|
-16.60% |
|
-50% |
-28.50% |
|
-29.40% |
| Total |
|
12 |
4 |
4 |
14 |
|
34 |
| |
|
-33.30% |
-11.10% |
-11.10% |
-38.80% |
|
|
| |
|
|
|
|
|
|
|
| Voriconazole (1µg) |
S |
10 |
3 |
- |
9 |
2 |
24 |
| |
|
-83.30% |
-75.00% |
|
-64.20% |
-100.00% |
-75.00% |
| |
SDD |
0 |
1 |
- |
0 |
0 |
1 |
| |
|
|
-25.00% |
|
|
|
-3.10% |
| |
R |
2 |
0 |
- |
5 |
0 |
7 |
| |
|
-16.60% |
|
|
-35.70% |
|
-21.80% |
| |
Total |
12 |
4 |
|
14 |
2 |
32 |
| |
|
-37.50% |
-12.50% |
|
-43.70% |
-6.20% |
|
Table 2. Antifungal Susceptibility Pattern of Candida species
Figure 3: Antifungal susceptibility testing of Candida spp.
[Fluconazole resistance and voriconazole susceptible.
Discussion
Candida albicans is considered as a normal flora on the mucous
membrane of the oral cavity, alimentary canal, urogenital tract
and integumentary system of healthy individuals. They can also
act as an opportunistic pathogen and responsible for causing both
superficial and systemic infections [7]. But from few years, there
has been a notable increase in infections caused by non-albicans Candida (NAC). There are altogether 200 species of Candida of
which C. dubliniensis, C. glabrata, C. parapsilosis, C. tropicalis,
C. krusei, C. lusitaniae, C. kefyr and C. auris are NACs that have
gained clinical significance [8]. Most of these NACs with clinical
importance are known to show resistance to certain commonly
used antifungal agents. So, for optimizing the treatment of the
infections caused by Candida species, it is necessary to identify
the Candida species up to the species level and perform antifungal
susceptibility testing [9].
This study identified the specific species of Candida along with
their antifungal susceptibility pattern. C. albicans and NAC
are closely related but they differ from each other in term of
their epidemiology, virulence characteristics and antifungal
susceptibility. In our study, the culture positivity rate is 7.68 %
and most of the cases were reported from the age group 30-40.
A similar but contradictory result was shown by Saud in which
most of the cases were found in the age group 46-55 years [10 ].
This might be due to differences in sample size, study duration,
study area, study type and so on. Colonization of Candida species
in females was found to be three times higher than the males (i.e.
34, 75.55% in females and 11, 24.44% in males). The probable
cause for higher candiduria in females than males may be due to
the urethral anatomy and hormonal factors that contribute the
colonization of Candida species in the urethral area in females
[11,12].
The rate of isolation of NAC causing UTI was found to be 73.3%
in our study, which is higher than other studies conducted in
Nepal and India [9,13]. Among the 45 Candida isolates, the most
predominant was C. parapsilosis (14, 31.1%) which aligns with
the findings of study done by Sajjan in Nepal [14]. Following
C. parapsilosis, C. albicans was the second most prevalent
species (26.6%, 12), while C. kefyr, C. glabrata, C. tropicalis, C.
dubliniensis, and C. krusei accounted for varying proportions
of isolates. Our findings present a different scenario regarding
the frequency of Candida species compared to previous two
independent studies from Nepal showing C. albicans as the
most prevalent one [10,13]. A relatively higher proportion of
C. parapsilosis isolates in our study may be related to a higher
sample size and other factors including the improved laboratory
diagnosis, type of patient population studied, previous exposure
to polyene and azole agents, changing demographics pattern of
patients (older age, increased environmental exposure), use of
indwelling medical devices, study duration, study area, methods
of identification, study type, study time and so on. Overall,
the present study along with the findings of other researchers
suggests the emergence of NAC for Candiduria. Therefore,
increasing awareness about fungal infections and their impact
on health within community is crucial to reduce the burden of
disease. The identification of Candida has a paramount effect on
successful treatment, as it helps to optimize the selection of the
therapeutic agent and the use of CHROM agar is a simple, rapid,
and inexpensive method for the identification of Candida species,
especially in the laboratory with limited resources settings. The
risk factors associated with Candiduria must be kept in mind for
both the clinician and laboratory personnel.
Furthermore, a study with a larger samples sizes and followup
for outcome would contribute to better understanding of
prognosis and response. In conclusion, the correct identification
of Candida species is of utmost importance due to its prognostic
and therapeutic significance, facilitating early and appropriate
antifungal therapy.
In our study, the rate of fluconazole resistant isolates was found
to be 29.4%. A similar study conducted in Nepal showed slightly
lower (20%) fluconazole resistance isolates [15]. The two different
studies conducted in India by Pramodhini and Yashavanth
showed the fluconazole resistant profile as 22.72% and 24%
respectively[16 ,17] but a study in Cameroon showed fluconazole
resistant rate of 42% [18]. Among the different Candida species,
the highest rate of fluconazole resistance was observed in C.
glabrata (2/4, 50.0%) followed by C. parapsilosis (4/14, 28.5%)
while its rate is only 16.6% for C. albicans. Similarly, the rate of
voriconazole resistant isolates were 21.8% in our study which is
more or less similar to the study conducted in India by Yashavanth
in 2012 (18.1%) [17] But it is lower than study conducted by
Pramodhini (12.9%) in 2021 [16]. The antifungal susceptibility
test shows that voriconazole (75.0%) was more effective than
fluconazole (52.7%). In fact, fluconazole and voriconazoleresistant
Candida species are rising in the community. The
exact reasons for this high resistance is unclear, but it could be
due to the easy availability, irrational use, and consumption
without proper consultation with clinicians and limited access
to diagnostic centers for fungus culture and identification. Thus,
this study emphasizes the need for speciation of Candida isolates
and recommends performing antifungal susceptibility for all the
clinical isolates.
Conclusion
The shift from Candida albicans to NAC as a predominant
species causing candiduria, along with increased resistance to
fluconazole, raises concerns about a potential paradigm shift in
candiduria. This limit the effectiveness of treatment options and
lead to persistent or recurrent infections, increased healthcare
cost, and higher morbidity and mortality rates. Hence, it is
important to implement appropriate antifungal stewardship
program to optimize antifungal use, implement infection control
practices and promote research efforts to combat this emerging
problem otherwise we have to again asked the question do
we verge facing the antifungal resistance same as antibacterial
resistance?